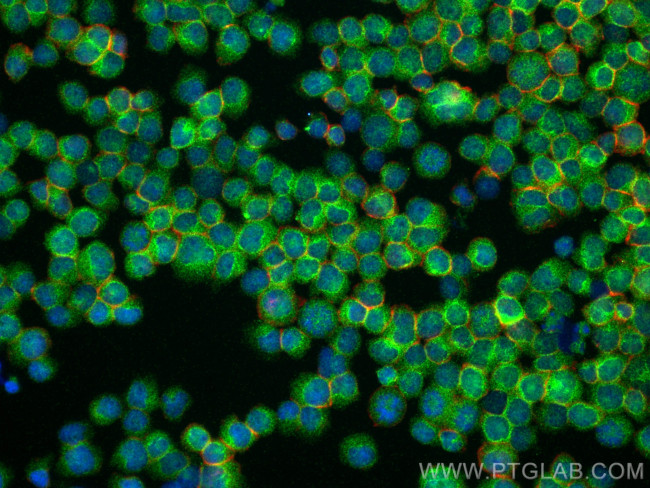
SHARPIN Antibody in Immunocytochemistry (ICC/IF)

Search
Proteintech
SHARPIN Polyclonal Antibody
{{$productOrderCtrl.translations['antibody.pdp.commerceCard.promotion.promotions']}}
{{$productOrderCtrl.translations['antibody.pdp.commerceCard.promotion.viewpromo']}}
{{$productOrderCtrl.translations['antibody.pdp.commerceCard.promotion.promocode']}}: {{promo.promoCode}} {{promo.promoTitle}} {{promo.promoDescription}}. {{$productOrderCtrl.translations['antibody.pdp.commerceCard.promotion.learnmore']}}
产品信息
14626-1-AP
种属反应
已发表种属
宿主/亚型
分类
类型
抗原
偶联物
形式
浓度
规格
纯化类型
保存液
内含物
保存条件
运输条件
产品详细信息
Immunogen sequence: MAPPAGGAA AAASDLGSAA VLLAVHAAVR PLGAGPDAEA QLRRLQLSAD PERPGRFRLE LLGAGPGAVN LEWPLESVSY TIRGPTQHEL QPPPGGPGTL SLHFLNPQEA QRWAVLVRGA TVEGQNGSKS NSPPALGPEA CPVSLPSPPE ASTLKGPPPE ADLPRSPGNL TEREELAGSL ARAIAGGDEK GAAQVAAVLA QHRVALSVQL QEACFPPGPI RLQVTLEDAA SAASAASSAH VALQVHPHCT VAALQEQVFS ELGFPPAVQR WVIGRCLCVP ERSLASYGVR QDGDPAFLYL LSAPREAPAQ LVLSFLHLHQ CPRPPWL (1-326 aa encoded by BC025244)
靶标信息
Component of the LUBAC complex which conjugates linear polyubiquitin chains in a head-to-tail manner to substrates and plays a key role in NF-kappa-B activation and regulation of inflammation. LUBAC conjugates linear polyubiquitin to IKBKG and RIPK1 and is involved in activation of the canonical NF-kappa-B and the JNK signaling pathways. Linear ubiquitination mediated by the LUBAC complex interferes with TNF-induced cell death and thereby prevents inflammation. LUBAC is proposed to be recruited to the TNF-R1 signaling complex (TNF-RSC) following polyubiquitination of TNF-RSC components by BIRC2 and/or BIRC3 and to conjugate linear polyubiquitin to IKBKG and possibly other components contributing to the stability of the complex. Together with FAM105B/otulin, the LUBAC complex regulates the canonical Wnt signaling during angiogenesis.
仅用于科研。不用于诊断过程。未经明确授权不得转售。
生物信息学
蛋白别名: hSIPL1; mSIPL1; protein kinase C-interacting protein RBCC like 1; SHANK-associated RH domain interacting protein; Shank-associated RH domain-interacting protein; shank-interacting protein; Shank-interacting protein-like 1; Sharpin; unnamed protein product
基因别名: 0610041B22Rik; AIFID; AW121341; Conneck1; Cpdm; PSEC0216; RBCKL1; SHARPIN; SIPL1
UniProt ID: (Human) Q9H0F6, (Rat) Q9EQL9, (Mouse) Q91WA6
Entrez Gene ID: (Human) 81858, (Rat) 81859, (Mouse) 106025